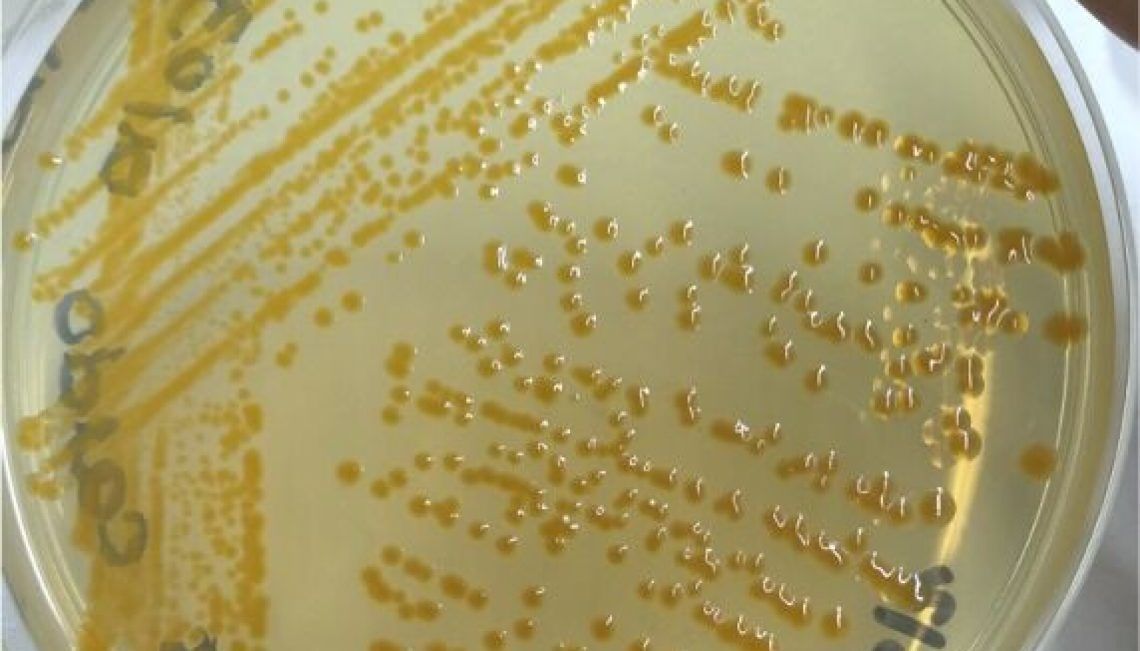
SalmonBusiness tweet media

S. quinqueradiata
45.1K posts


S. quinqueradiata
@FNinKochi
ほぼ閲覧と日常の些細なつぶやき。音声入力が多いため、誤字脱字はお許しください。つぶやきは個人の発言です。写真・動画等の利用には、一言連絡ください。
太平洋側 Katılım Temmuz 2012
821 Takip Edilen7K Takipçiler
Sabitlenmiş Tweet

この蒸留キットいいなぁ。
自分でいろんな香りを作れそう。
yasu l 巴波重工@Shyasuna
高知でポンカンの減圧蒸留。 とんでもなくジューシーで甘い香りの蒸留水が無限に取れる。ポンカンすごすぎる。
日本語

塗ってましたね〜
申請区分で色が違うから、それ用にマジックを買いました。
岡島昭浩@okjma
全く忘れてたけど、科研費の申請書を紙で出してたころ、右上を塗り分けて、というアナログな要求があったのでした。 これは2006年。
日本語

食べログの見方としては、点数が正規分布に近い形であれば、なんとなく評価としては正しいのだろうとして見ています。そして、だいたいの場合、その平均値よりも上に感じる事が多いです。二峰性な分布(5点と1点が多い)だと怪しいな...と、私は避けます。
多田水産(の中の人)@tada2547
この方のツイートが流れてきて、ウチの店の点数どんなもんなんやろとめちゃくちゃ久しぶりに食べログ覗きに行ったら「3.48」でした。ちゃんとしたお店の範囲内なのか🤔
日本語
S. quinqueradiata retweetledi

Researcher: new Flavobacterium strain isolated from hatchery water : Researchers from three Chilean institutions have identified a new Flavobacterium species, F. maulense, isolated from water used in Atlantic salmon alevin cultivation.
buff.ly/jUm0xP3
English
S. quinqueradiata retweetledi
S. quinqueradiata retweetledi
S. quinqueradiata retweetledi

@toyosu_shijou 昔(2008)、東海大学で春の水産学会が開催された時、居酒屋等でいろいろ食べた。きっと冷凍ものだったとは思うけど、美味しかった。サクラエビの資源管理はしっかりしてますね。
日本語
S. quinqueradiata retweetledi

「佐渡さくらます」8年目の販売開始 成育良好で最多130トン販売見込む 山津水産 - 水産経済新聞
suikei.co.jp/archives/102869
日本語

地乳を使ったソフトクリーム
多田水産さんも入っている、須崎の道の駅
それから、のいち動物公園でも食べることができます。
牛乳はだいたいの地元のスーパーで取扱があります。
Kozue Kurahashi@ksn8099rang242q
今日は白の日。城もいいけど牛乳の白もいいですね。先日、高知に行った際に目に付いたのが地酒ならぬ「地乳」という文字。「ぢちち」と読むそうです。初めて見ました。こういう地域密着の牛乳は魅力的。昔ながらの瓶で販売されてるのも地乳が多いですね。日本にはまだ知らない牛乳があるんでしょうね。
日本語
S. quinqueradiata retweetledi








